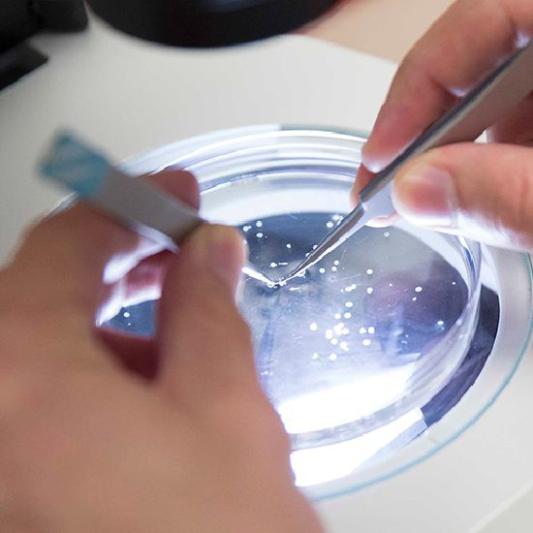

Lipscomb Health
Encompassing Lipscomb University’s health care programs, partnerships and initiatives, Lipscomb Health prepares health professionals and administrators to serve local and global health care needs. Focused on interprofessional education, collaborative care and clinical experience through a network of local partners, Lipscomb Health equips students for a lifetime of professional practice marked by compassionate care.
As an institution that integrates Christian faith and practice with academic excellence, Lipscomb University is a nationally ranked Christian university with an unwavering commitment to equipping students for lives of purpose, marked by intellectual, spiritual and vocational flourishing. A critical component of this mission is health sciences education that prepares competent, compassionate health professionals trained to deliver quality care that leads to healing. Lipscomb Health accomplishes this work through rigorous education, professional practice and relevant research that elevates the profession, enhances partnerships and empowers people.
What We Do
Elevate the Profession
Lipscomb Health faculty also practice in local clinical settings and contribute to the body of knowledge for the Health Sciences by conducting relevant research in their areas of interest and expertise. This combination of knowledge in practice means Lipscomb Health faculty can prepare future health care professionals ready to reach new levels of excellence.
Enhance Partnerships
As a contributor to Nashville’s reputation as the health care capital of America, Lipscomb Health capitalizes on the opportunities in our city to collaborate with leading organizations who are influencing the future of health care. These partnerships create opportunities for faculty and students to participate in clinical practice in a variety of health care settings.
Empower People
Through interprofessional education, collaborative care and clinical experience working with local partners, Lipscomb Health equips students for a lifetime of professional practice marked by compassionate care. By mentoring and investing in the next generation of health care professionals, Lipscomb Health empowers students to influence the world around them.
Academic Programs
Looking to launch your career as a mover-and-shaker in the health care industry? Check out all that Lipscomb Health has to offer, and choose the program that’s right for you.
Undergraduate Programs

Take courses from a variety of disciplines to gain a holistic, practical knowledge of dietetics. Learn about where food comes from, how its preparation affects its nutritional value and how it is processed by the human body. Apply your skills in community service and engagement.
Visit Program Page
Earn a degree that will pave your career path as a physical or occupational therapist, physician assistant, chiropractor, nurse or any other professional health field you could imagine. When you graduate, you’ll join the rest of your peers who landed careers in the field or were admitted to the allied health graduate schools of their choice.
Visit Program Page
Kick your future into high gear with a degree in fitness and sports studies. This unique program combines the fundamentals of kinesiology with courses in business and psychology to equip you with all the skills you’ll need to thrive in the fields of fitness, wellness and strength and conditioning.
Visit Program Page
Learn cellular, molecular and anatomical aspects of neurobiology while also gaining insight into the influence of this biology on behavior. Prepare for a health care career, graduate programs in psychology, behavioral science and neuropsychology, or laboratory research.
View Program Page
Here, you'll get a high-quality education in medical-surgical courses and all specialty areas, including critical care, obstetrics, pediatrics, mental health and community-based learning. “Practice before you practice" in our on-campus, state-of-the-art high-fidelity patient simulation lab. Begin learning in the health care capital of the U.S.
Visit Program Page
The demand for ethical, brilliant physicians is always high. Our distinguished faculty will guide you through rigorous coursework in the specifics of biology, chemistry and physics. You’ll have access to state-of-the-art labs and research opportunities, giving you a sneak peak into the world of medical school.
Visit Program Page
Develop and carry out plans for patients recovering from illness and injury. Work alongside of clients to improve and maintain their functionality for everyday tasks. With your Pre-Occupational Therapy focus, you will be given opportunities to assess, analyze and create strategies for improvement in a variety of patients.
Visit Program Page
Let us prepare you to deliver proper care regarding all types of physical injuries. Within Pre-Physical Therapy, you will begin with a foundational knowledge of relevant sciences — biology, chemistry, physics, anatomy and kinesiology. Even more, our faculty will assure that you have all the necessary requirements for your future professional school of choice.
Visit Program Page
We know psychology has practical application in every facet of life. And, it provides a strong foundation for many career paths. In order to be fully equipped for your career goals, our broad curriculum allows you to explore your personal interests and take advantage of research and internship opportunities.
Visit Program Page
With its three major league teams and four Division I NCAA schools, Nashville is the perfect city for you to score shadowing experience, internships and jobs. Study in a program that provides you with a comprehensive business education and the added exercise science knowledge to elevate your expertise.
Visit Program Page
Whether you want to work in mental health, foster care and adoption, crisis intervention, health care, a school or other sectors, you'll receive the training you need to succeed. Our classrooms hold state-of-the-art technology that will prepare you for your 500 hours of supervised field practicum work and future career.
Visit Program PageGraduate Programs
Whether you want to enter clinical science or the allied health sciences, we'll work with you to ensure you are a stronger applicant and a valuable asset in the market. 80 percent of our pre-med grads who applied to medical school have a checkmark by that accomplishment, and our Ph.D. acceptance rate is over 90 percent. Take part in biomedical research and enhance your professional edge!
Visit Program Page
The cardiovascular perfusion curriculum prepares you to enter a highly skilled and desired position within the surgical theater. The partnerships Lipscomb has developed all around the country will ensure you have the highest quality clinical placements during your education and provide you excellent job opportunities after graduation.
Visit Program Page
Learn how to touch lives in meaningful ways that only a trained counselor can. Walk with clients as they navigate life’s challenges. With a curriculum built around licensure expectations and a 100 percent pass rate, you'll be prepared to excel.
Visit Program Page
There’s never been a better time for health professionals in today’s world, and we know you want to set yourself apart. Approach health holistically by studying in a program that combines the interrelated fields of exercise science and human performance.
Visit Program Page
There are over 900 companies working in health care in Nashville with sway over the worldwide industry. Learn to be a leader in a city at the forefront of health care practice, business and technology. Here, you'll be an eyewitness to the future of the field and the latest advances in delivering health care.
Visit Program Page
Enhance and transform health care delivery and outcomes. Become equipped to improve quality of care and reduce health care costs, making the industry more efficient and economical. Nashville, widely known as the health care industry’s capital, is the perfect place to start.
Visit Program Page
Your rigorous training to become a caring and compassionate therapist will prepare you to serve individuals overcoming their mental health challenges, help couples restore a thriving relationship, and lead families to create healthy and effective family processes.
Visit Program Page
Your passion is to help others bring about a healthier lifestyle through diet and nutrition. We provide experiences to prepare you to become a registered dietitian through our Master of Science in Nutrition and Dietetic Internship Program (MS DI). Whether your interest is clinical, outpatient, community, wellness, sports nutrition or food service operations, we’ll ensure you reach your goal.
Visit Program Page
Build the knowledge you need to be a pharmacist and gain the versatility you need to advance your career. Let our expert faculty share their clinical knowledge embodied with Christian values. So join the pharmacists who dive the deepest when it comes to caring for communities.

Let us help you prepare for a career of service. Take advantage of our small class sizes and state-of-the-art facilities. Get to know the health care community through experience in area hospitals and labs. Our PA program will serve your spiritual and vocational goals as you train to serve others.
Visit Program Page
Analytics is important in any field, but especially sport. Grow your skills in sport analytics to play a key role in professional and collegiate arenas, as well as other entertainment and sport careers.
Visit Program PageMore About Lipscomb Health
Take the
Next Step.
Join our community of purposeful minds and passionate hearts.